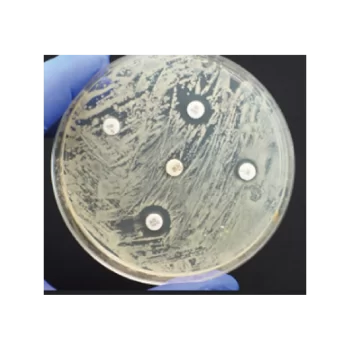
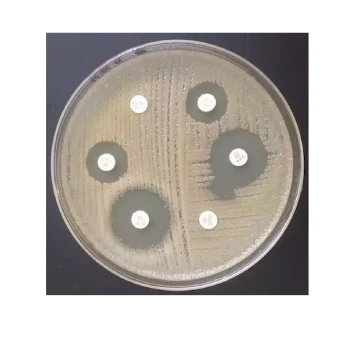
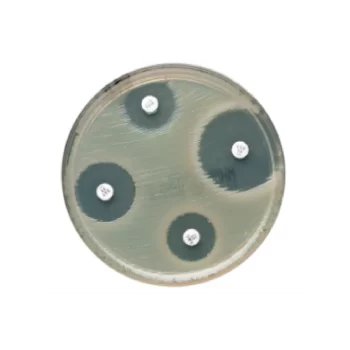
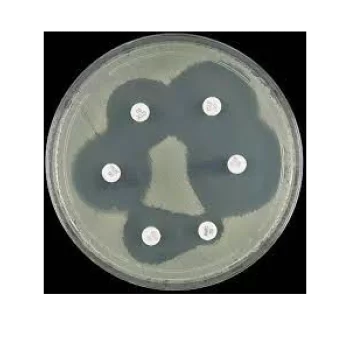
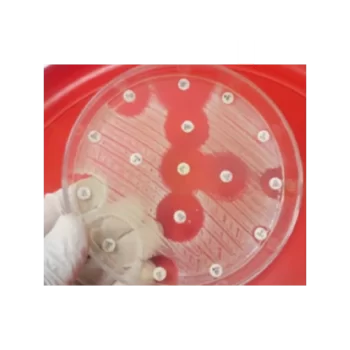
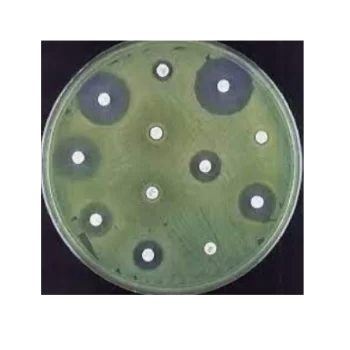

Showing 127–135 of 194 results
Oxoid™ Gentamicin Antibiogram Discs / Discos para antibiograma con gentamicina Oxoid™
S/ 0.00
[SKU: CT0072B]
Evalúe la sensibilidad de los microorganismos utilizando métodos AST manuales, con la ayuda de una amplia selección de discos para antibiogramas.
Oxoid™ Gentamicin Antimicrobial Susceptibility Discs / Discos de susceptibilidad antimicrobiana a gentamicina Oxoid™
S/ 0.00
[SKU: CT0024B]
Determine manualmente la susceptibilidad a los antibióticos de los microorganismos mediante métodos de prueba de susceptibilidad a los antimicrobianos (AST) junto con discos de susceptibilidad a los antimicrobianos de gentamicina Thermo Scientific™ Oxoid™ fiables y fáciles de usar.
Oxoid™ Hektoen Enteric Agar / Agar entérico Oxoid™ Hektoen
S/ 0.00
[SKU: CM0419B]
Aislar y diferenciar Shigella y Salmonella spp. a partir de muestras patológicas entéricas con agar entérico Thermo Scientific™ Oxoid™ Hektoen (deshidratado). El agar entérico Hektoen fue desarrollado por King y Metzger 1 .
Oxoid™ Hemoglobin Soluble Powder / Polvo soluble de hemoglobina Oxoid™
S/ 0.00
[SKU: LP0053C]
Oxoid Hemoglobin Powder Soluble es una hemoglobina especialmente preparada para su uso en medios de cultivo.
Oxoid™ Imipenem Antimicrobial Susceptibility discs / Discos de susceptibilidad antimicrobiana Oxoid™ Imipenem
S/ 0.00
[SKU: CT0455B]
Determine manualmente la susceptibilidad a los antibióticos de los microorganismos mediante métodos de prueba de susceptibilidad a los antimicrobianos (AST) junto con discos de susceptibilidad a los antimicrobianos Thermo Scientific™ Oxoid™ Imipenem, confiables y fáciles de usar.
Oxoid™ Kanamycin Antimicrobial Susceptibility discs / Discos de susceptibilidad antimicrobiana a la kanamicina Oxoid™
S/ 0.00
[SKU: CT0026B]
Evalúe la sensibilidad de los microorganismos utilizando métodos AST manuales, con la ayuda de una amplia selección de discos para antibiogramas.
Oxoid™ Levofloxacin Antimicrobial Susceptibility discs / Discos de susceptibilidad antimicrobiana a levofloxacina Oxoid™
S/ 0.00
[SKU: CT1587B]
Determine manualmente la susceptibilidad a los antibióticos de los microorganismos mediante métodos de prueba de susceptibilidad a los antimicrobianos (AST) junto con discos de susceptibilidad a los antimicrobianos de levofloxacina Thermo Scientific™ Oxoid™ fiables y fáciles de usar.
Oxoid™ Lincomycin/Neomycin Antibiogram Disks, 75 µg / Discos para antibiogramas con lincomicina/neomicina Oxoid™, 75 µg
S/ 0.00
[SKU: CT1757B]
Evalúe la sensibilidad de los microorganismos utilizando métodos AST manuales, con la ayuda de una amplia selección de discos para antibiogramas.
Oxoid™ Linezolid Antimicrobial Susceptibility discs / Discos de susceptibilidad antimicrobiana Oxoid™ Linezolid
S/ 0.00
[SKU: CT1650B]
Determine manualmente la susceptibilidad a los antibióticos de los microorganismos mediante métodos de prueba de susceptibilidad a los antimicrobianos (AST) junto con discos de susceptibilidad a los antimicrobianos Thermo Scientific™ Oxoid™ Linezolid confiables y fáciles de usar.